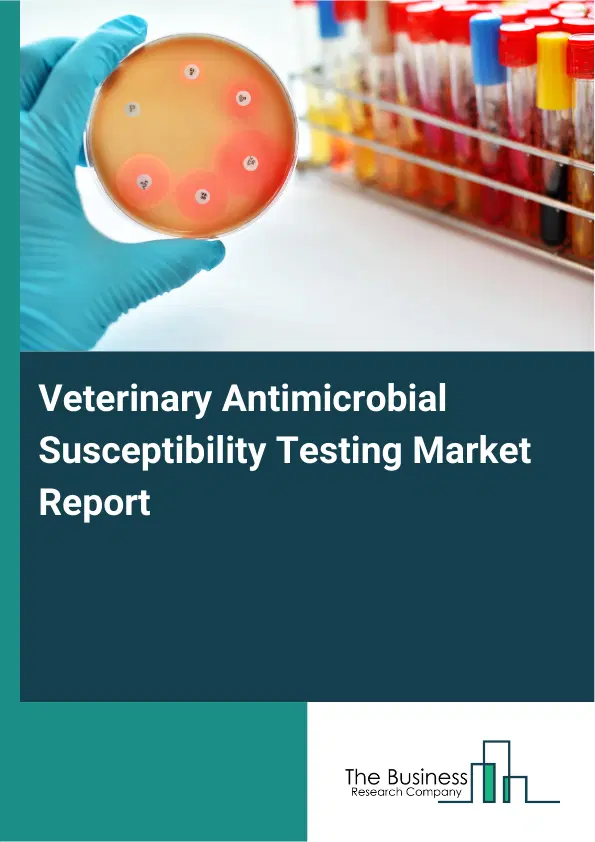
Global Veterinary Antimicrobial Susceptibility Testing Market Report 2026 Global Veterinary Antimicrobial Susceptibility Testing Market Report 2026

Veterinary Antimicrobial Susceptibility Testing Market Report 2026
Veterinary Antimicrobial Susceptibility Testing Market Report 2026
Global Outlook – By Product Type (Disks And Plates, Culture Media, Accessories And Consumables, Automated Antimicrobial Susceptibility Test (AST) Instruments ), By Animal Type (Livestock Animals, Companion Animals ), By End-Use (Veterinary Reference Lab, Veterinary Research Institutes, Other End-Users) – Market Size, Trends, Strategies, and Forecast to 2035
Veterinary Antimicrobial Susceptibility Testing Market Overview
• Veterinary Antimicrobial Susceptibility Testing market size has reached to $39.63 billion in 2025 • Expected to grow to $57.94 billion in 2030 at a compound annual growth rate (CAGR) of 7.9% • Growth Driver: The Surge In Pet Ownership Driving Veterinary Antimicrobial Susceptibility Testing Market • Market Trend: Innovative Rapid Tests In The Veterinary Antimicrobial Susceptibility Testing Market • North America was the largest region in 2025.What Is Covered Under Veterinary Antimicrobial Susceptibility Testing Market?
Veterinary antimicrobial susceptibility testing refers to a critical tool for the veterinarian in choosing the best drug to treat bacterial infections in animals. Veterinary antimicrobial susceptibility testing is used to provide a treatment history, including any previously used specific antibiotics as well as any clinical background that might have an impact on the patient's typical bacterial flora. The main product types of veterinary antimicrobial susceptibility testing are disks and plates, culture media, accessories and consumables, and automated AST (antimicrobial susceptibility test) instruments. Disks and plates refer to a little circular piece of filter paper that has been dipped in an antibiotic solution and left to dry. Disks and plates are used to identify the antibiotics that an infectious organism is sensitive to so that medical professionals can give the right medication. The animal types included are livestock and companion animals, that are tested in testing veterinary reference lab, veterinary research institutes, and others.
What Is The Veterinary Antimicrobial Susceptibility Testing Market Size and Share 2026?
The veterinary antimicrobial susceptibility testing market size has grown strongly in recent years. It will grow from $39.63 billion in 2025 to $42.73 billion in 2026 at a compound annual growth rate (CAGR) of 7.8%. The growth in the historic period can be attributed to establishment of veterinary diagnostic labs, rising prevalence of bacterial infections in livestock, limited awareness of antimicrobial resistance, traditional culture-based testing methods, government regulations supporting animal health.What Is The Veterinary Antimicrobial Susceptibility Testing Market Growth Forecast?
The veterinary antimicrobial susceptibility testing market size is expected to see strong growth in the next few years. It will grow to $57.94 billion in 2030 at a compound annual growth rate (CAGR) of 7.9%. The growth in the forecast period can be attributed to advancement in automated ast technologies, increasing adoption of precision medicine in veterinary care, growing companion animal population, rising investments in veterinary research, integration of cloud-based diagnostic data management. Major trends in the forecast period include rapid adoption of automated ast instruments, increasing demand for companion animal healthcare, growing awareness of antimicrobial resistance, expansion of veterinary reference laboratories, integration of advanced diagnostic workflows.Global Veterinary Antimicrobial Susceptibility Testing Market Segmentation
1) By Product Type: Disks And Plates, Culture Media, Accessories And Consumables, Automated Antimicrobial Susceptibility Test (AST) Instruments 2) By Animal Type: Livestock Animals, Companion Animals 3) By End-Use: Veterinary Reference Lab, Veterinary Research Institutes, Other End-Users Subsegments: 1) By Disks And Plates: Antibiotic Disks, Agar Plates 2) By Culture Media: Selective Culture Media, General Purpose Media 3) By Accessories And Consumables: Incubators, Sterilization Equipment, Pipettes And Reagents 4) By Automated Antimicrobial Susceptibility Test (AST) Instruments: Fully Automated Systems, Semi-Automated SystemsWhat Is The Driver Of The Veterinary Antimicrobial Susceptibility Testing Market?
An increase in pet ownership increases the focus on animal welfare and animal health which is expected to propel the veterinary antimicrobial susceptibility testing market going forward. Pet ownership refers to the act of having and caring for a domesticated animal as a companion or member of the family. Pet ownership is rising because people seek emotional companionship, leading more households to adopt pets for stress relief and improved mental well-being. Veterinary antimicrobial susceptibility testing helps pet ownership by ensuring effective treatment of infections, reducing illness duration, and maintaining the health and well-being of pets. For instance, in 2023, according to the Shelter Animals Count, a US-based non-governmental organization, of the animals in shelters and rescues in 2023, 4.8 million were adopted into loving homes. Therefore, an increase in pet ownership is driving the veterinary antimicrobial susceptibility testing industry.Key Players In The Global Veterinary Antimicrobial Susceptibility Testing Market
Major companies operating in the veterinary antimicrobial susceptibility testing market are BioMérieux SA, Becton, Dickinson and Company, Bio-Rad Laboratories, Bruker Corporation, Condalab SA, FASTinov SA, Hardy Diagnostics Co., HiMedia Laboratories, Liofilchem Srl, Mast Group Ltd., Neogen Corporation, SSI Diagnostica A/S, Synbiosis, Thermo Fisher Scientific Inc., Accelerate Diagnostics Inc., Alifax S.r.l., Biogal Galed Labs Ltd., Creative Diagnostics, Danaher Corporation, Eurofins Scientific SE, IDEXX Laboratories Inc., Merck Co. & KGaA, Microbiologics Inc., QIAGEN N.V., R-Biopharm AG, T2 Biosystems Inc., Vetoquinol S.A., Virbac Inc., Zoetis Inc.Global Veterinary Antimicrobial Susceptibility Testing Market Trends and Insights
Major companies operating in the veterinary antimicrobial susceptibility testing market are launching innovative products such as a rapid test to sustain their position in the market. A rapid test, also known as a rapid diagnostic test (RDT) or rapid assay, is a diagnostic procedure designed to provide quick results within a short period. For instance, in March 2023, PDX Biotech LLC, a US-based biotechnology company launched rapid test, the OraStripdx, that can detect active periodontal disease in dogs and cats in 10 seconds. The OraStripdx features an easy-to-use test strip that changes color based on the concentration of thiols in the patient’s oral fluid and the test requires no anesthesia or sedation. The OraStripdx test strip detects the development of disease where it cannot be directly visualized and can help pet owners and their health care providers to detect the diseases in the earliest stages which is a major advantageWhat Are Latest Mergers And Acquisitions In The Veterinary Antimicrobial Susceptibility Testing Market?
In September 2023, Mars, Incorporated, a US–based diversified manufacturing and pet health company, acquired SYNLAB Vet for an undisclosed amount. With this acquisition, Mars aimed to expand its veterinary diagnostics and technology capabilities across Europe and strengthen its pet healthcare solutions offering within its Mars Petcare Science & Diagnostics division. SYNLAB Vet is a Germany–based veterinary diagnostics company that specializes in providing specialist veterinary laboratory diagnostic services and related technology solutions to veterinary professionals.Regional Outlook
North America was the largest region in the veterinary antimicrobial susceptibility testing market in 2025. The regions covered in this market report are Asia-Pacific, South East Asia, Western Europe, Eastern Europe, North America, South America, Middle East, Africa. The countries covered in this market report are Australia, Brazil, China, France, Germany, India, Indonesia, Japan, Taiwan, Russia, South Korea, UK, USA, Canada, Italy, SpainWhat Defines the Veterinary Antimicrobial Susceptibility Testing Market?
The veterinary antimicrobial susceptibility testing market consists of revenues earned by entities by providing the disk diffusion technique and the broth dilution technique. The market value includes the value of related goods sold by the service provider or included within the service offering. Only goods and services traded between entities or sold to end consumers are included.How is Market Value Defined and Measured?
The market value is defined as the revenues that enterprises gain from the sale of goods and/or services within the specified market and geography through sales, grants, or donations in terms of the currency (in USD unless otherwise specified). The revenues for a specified geography are consumption values that are revenues generated by organizations in the specified geography within the market, irrespective of where they are produced. It does not include revenues from resales along the supply chain, either further along the supply chain or as part of other products.Veterinary Antimicrobial Susceptibility Testing Market Report Forecast Analysis
| Report Attribute | Details |
|---|---|
| Market Size Value In 2026 | $42.73 billion |
| Revenue Forecast In 2035 | $57.94 billion |
| Growth Rate | CAGR of 7.8% from 2026 to 2035 |
| Base Year For Estimation | 2025 |
| Actual Estimates/Historical Data | 2020-2025 |
| Forecast Period | 2026 - 2030 - 2035 |
| Market Representation | Revenue in USD Billion and CAGR from 2026 to 2035 |
| Segments Covered | Product Type, Animal Type, End-Use |
| Regional Scope | Asia-Pacific, Western Europe, Eastern Europe, North America, South America, Middle East, Africa |
| Country Scope | The countries covered in the report are Australia, Brazil, China, France, Germany, India, ... |
| Key Companies Profiled | BioMérieux SA, Becton, Dickinson and Company, Bio-Rad Laboratories, Bruker Corporation, Condalab SA, FASTinov SA, Hardy Diagnostics Co., HiMedia Laboratories, Liofilchem Srl, Mast Group Ltd., Neogen Corporation, SSI Diagnostica A/S, Synbiosis, Thermo Fisher Scientific Inc., Accelerate Diagnostics Inc., Alifax S.r.l., Biogal Galed Labs Ltd., Creative Diagnostics, Danaher Corporation, Eurofins Scientific SE, IDEXX Laboratories Inc., Merck Co. & KGaA, Microbiologics Inc., QIAGEN N.V., R-Biopharm AG, T2 Biosystems Inc., Vetoquinol S.A., Virbac Inc., Zoetis Inc. |
| Customization Scope | Request for Customization |
| Pricing And Purchase Options | Explore Purchase Options |
Frequently Asked Questions
The Veterinary Antimicrobial Susceptibility Testing market was valued at $39.63 billion in 2025, increased to $39.63 billion in 2026, and is projected to reach $57.94 billion by 2030.
request a sample hereThe expected CAGR for the Veterinary Antimicrobial Susceptibility Testing market during the forecast period 2025–2030 is 7.9%.
request a sample hereMajor growth driver of the market includes: An increase in pet ownership increases the focus on animal welfare and animal health which is expected to propel the veterinary antimicrobial susceptibility testing market going forward. Pet ownership refers to the act of having and caring for a domesticated animal as a companion or member of the family. Pet ownership is rising because people seek emotional companionship, leading more households to adopt pets for stress relief and improved mental well-being. Veterinary antimicrobial susceptibility testing helps pet ownership by ensuring effective treatment of infections, reducing illness duration, and maintaining the health and well-being of pets. For instance, in 2023, according to the Shelter Animals Count, a US-based non-governmental organization, of the animals in shelters and rescues in 2023, 4.8 million were adopted into loving homes. Therefore, an increase in pet ownership is driving the veterinary antimicrobial susceptibility testing market. in the Veterinary Antimicrobial Susceptibility Testing market. For further insights on this market,
request a sample hereThe veterinary antimicrobial susceptibility testing market covered in this report is segmented –
1) By Product Type: Disks And Plates, Culture Media, Accessories And Consumables, Automated Antimicrobial Susceptibility Test (AST) Instruments
2) By Animal Type: Livestock Animals, Companion Animals
3) By End-Use: Veterinary Reference Lab, Veterinary Research Institutes, Other End-Users Subsegments:
1) By Disks And Plates: Antibiotic Disks, Agar Plates
2) By Culture Media: Selective Culture Media, General Purpose Media
3) By Accessories And Consumables: Incubators, Sterilization Equipment, Pipettes And Reagents
4) By Automated Antimicrobial Susceptibility Test (AST) Instruments: Fully Automated Systems, Semi-Automated Systems
request a sample here1) By Product Type: Disks And Plates, Culture Media, Accessories And Consumables, Automated Antimicrobial Susceptibility Test (AST) Instruments
2) By Animal Type: Livestock Animals, Companion Animals
3) By End-Use: Veterinary Reference Lab, Veterinary Research Institutes, Other End-Users Subsegments:
1) By Disks And Plates: Antibiotic Disks, Agar Plates
2) By Culture Media: Selective Culture Media, General Purpose Media
3) By Accessories And Consumables: Incubators, Sterilization Equipment, Pipettes And Reagents
4) By Automated Antimicrobial Susceptibility Test (AST) Instruments: Fully Automated Systems, Semi-Automated Systems
Major trend in this market includes: Innovative Rapid Tests In The Veterinary Antimicrobial Susceptibility Testing Market For further insights on this market,
request a sample hereMajor companies operating in the Veterinary Antimicrobial Susceptibility Testing market are Major companies operating in the veterinary antimicrobial susceptibility testing market are BioMérieux SA, Becton, Dickinson and Company, Bio-Rad Laboratories, Bruker Corporation, Condalab SA, FASTinov SA, Hardy Diagnostics Co., HiMedia Laboratories, Liofilchem Srl, Mast Group Ltd., Neogen Corporation, SSI Diagnostica A/S, Synbiosis, Thermo Fisher Scientific Inc., Accelerate Diagnostics Inc., Alifax S.r.l., Biogal Galed Labs Ltd., Creative Diagnostics, Danaher Corporation, Eurofins Scientific SE, IDEXX Laboratories Inc., Merck Co. & KGaA, Microbiologics Inc., QIAGEN N.V., R-Biopharm AG, T2 Biosystems Inc., Vetoquinol S.A., Virbac Inc., Zoetis Inc.
request a sample hereNorth America was the largest region in the veterinary antimicrobial susceptibility testing market in 2025. The regions covered in the veterinary antimicrobial susceptibility testing market report are Asia-Pacific, South East Asia, Western Europe, Eastern Europe, North America, South America, Middle East, Africa.
request a sample here